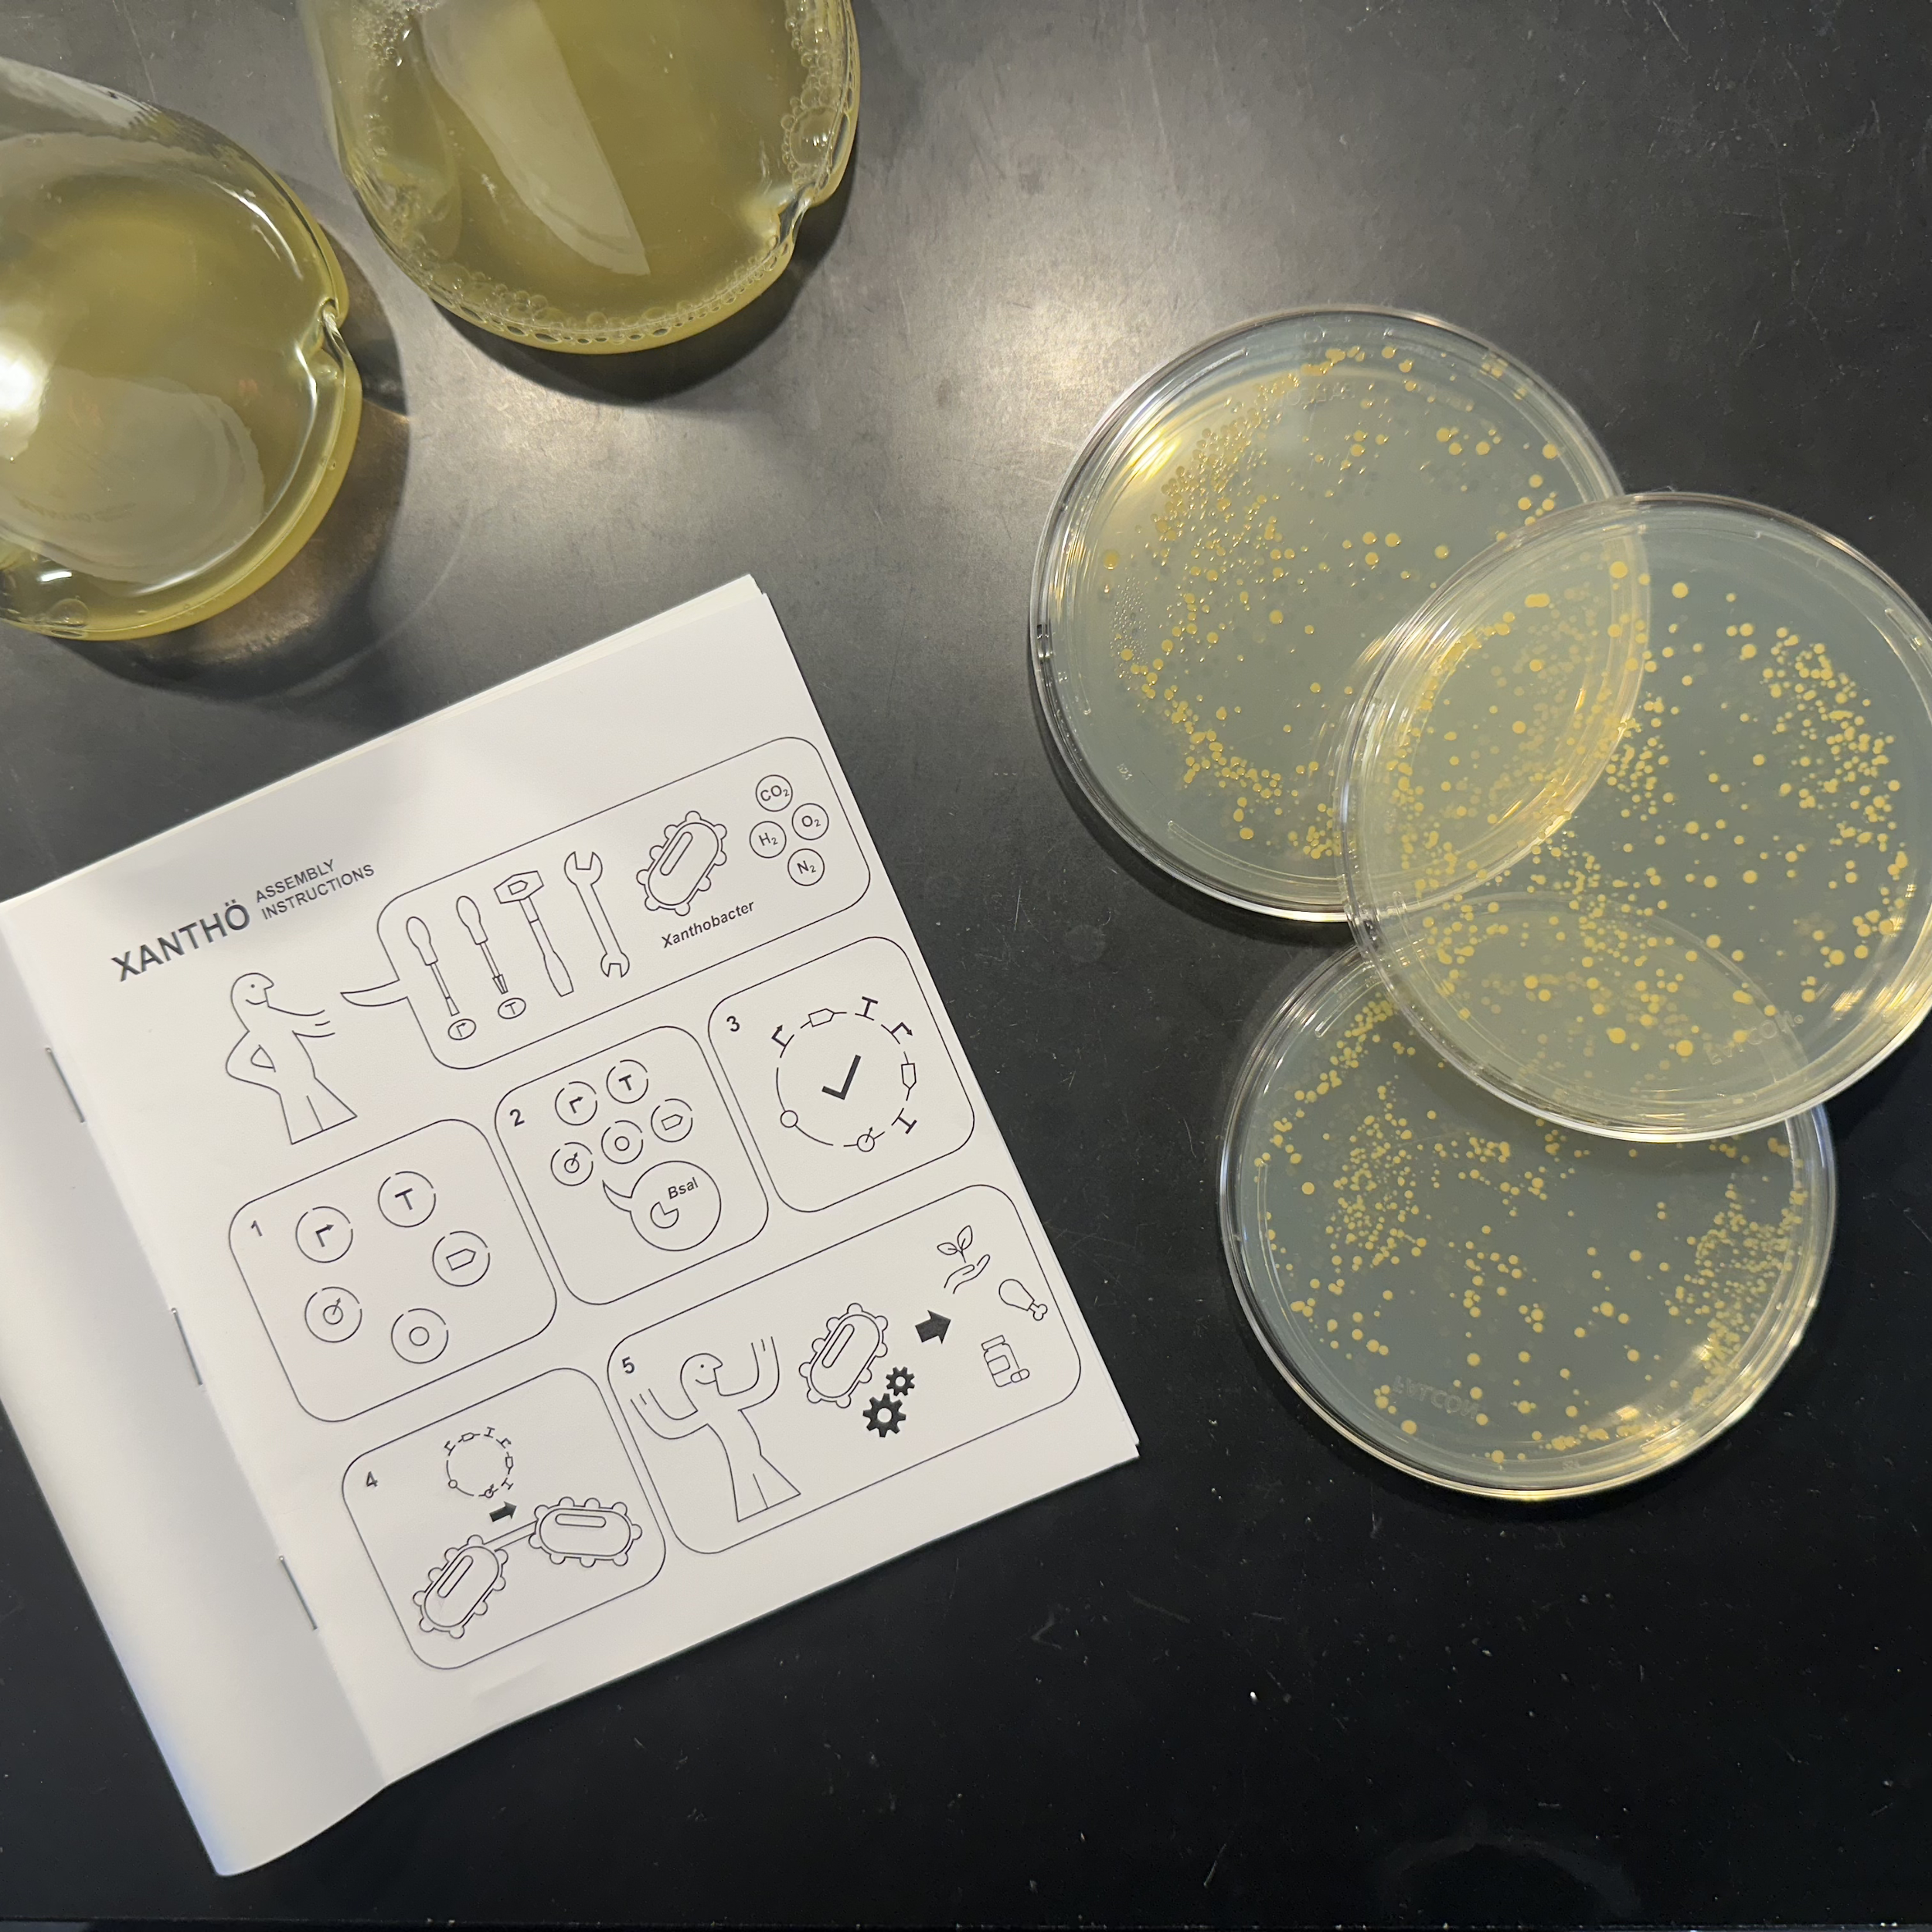

Our Research
Engineering biology for sustainability
How do we design strains to sustainably produce the commodities we need? We have been developing genetic tools for Xanthobacter, a genus that can grow at industrial scales on cheap, sustainable substrates.

Developing rare earth biomining
We are working to understand the metallobiology of rare earth elements in model and non-model soil microbes. This work will enable the development of sustainable rare earth biomining from low-grade feedstocks such as recycled electronic waste.

Carbon capture and sequestration
We are working on synthetic biology methods to enhance natural carbon capture and storage systems such as through rock weathering.

Diagnostic development, sample collection, and sample preservation
We are working to improve throughput and assay performance while reducing costs, enabling a wide range of diagnostics from at-home testing to environmental and agricultural applications.

Quantitative principles of cellular design and its underlying mechanisms
How do cell respond ‘appropriately’ to the environment? We use yeast as a model system to analyze this and have uncovered a number of design principles including a ratiometric sensor, flux-correlated signaling, and dimmer switches.
